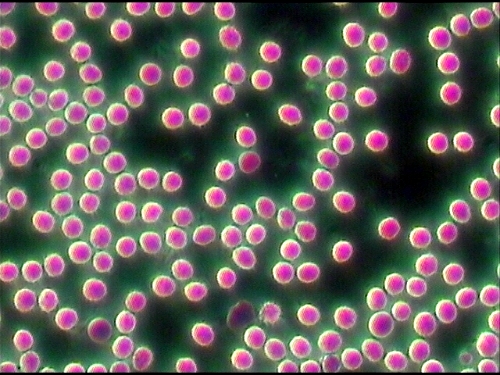

info@di-li.eu
Dunkelfeldmikroskope sind zur Zeit leider nicht lieferbar
Dunkelfeldmikroskope sind zur Zeit leider nicht lieferbar |
|
auch für Hellfeld 
|
Dunkelfeldmikroskop (Dark-Field) Di-Li
1030 Technische Daten: Optisches System: Anti-Fungus, Unendlichkorrigiert Stativ: stabiler und kippsicherer verbreiteter Druckguss-Fuß für bessere Stabilität. Tubus: Siedentopf trinokular, ergonomisch günstiger Einblickwinkel von 30°, 360° drehbar, Augenabstand verstellbar 52-75 mm Okulare: Weitfeld-Okulare WF 10x/20mm, Anti-Fungus Beschichtung Objektivrevolver: fünffach, nach hinten geneigt und kugelgelagert, 5 Objektive: Infinity DIN Plan-Achromatische Objektive, unendlich korrigiert, 4x, 10x, 20x, 40x (mit Feder) und 60x (mit Feder), Anti-Fungus Beschichtung Großer Kreuztisch 150mm, mit Präparathalter Kondensor: Dunkelfeld Kondensor N.A. 0,83-0,91 Zusätzlich Abbe-Kondensor NA 1.25 mit Irisblende für Hellfeld. Fokussierung: koaxialer Grob- und Feintrieb für präzise Fokussierung Beleuchtung: Köhler Beleuchtung Extrahelle LED -Full Köhler- Monitor: Hochauflösend 8 oder 15 Zoll CCD: Hochauflösend 1/3 Zoll, 625 lines In den meisten Fällen reicht der 8 Zoll Monitor. Gerade bei großen Vergrößerungen, erhalten Sie ein schärferes Bild. Geeignet als Medizinprodukt, EG-Konform nach EU-Richtlinie 93/42/EWG Klasse 1 -- Einführungspreise--
Wenn Sie Fragen haben, wir beraten Sie gerne 0631-78319 |
||||||||||
|
Dunkelfeldmikroskop (Dark-Field) Di-Li 1030-HD auch für Hellfeld Hochauflösender Kamera 
|
Dunkelfeldmikroskop Di-Li 1030-HD Monitor: Hochauflösend 8 Zoll oder 15 Zoll CCD: Hochauflösend 1/3 Zoll, 1024x768 USB bis 1600x1200 Am Monitor zusätzlich ein 10-fach Digitalzoom In den meisten Fällen reicht der 8 Zoll Monitor. Gerade bei großen Vergrößerungen, erhalten Sie ein schärferes Bild. Geeignet als Medizinprodukt, EG-Konform nach EU-Richtlinie 93/42/EWG Klasse 1 -- Einführungspreise--
Wenn Sie Fragen haben, wir beraten Sie gerne 0631-78319 |
||||||||||
|
Dunkelfeldmikroskop Phasenkontrastmikroskop Hellfeldmikroskop Di-Li 1030-P - Die Universallösung - 
|
Di-Li 1030-P - Dunkelfeldmikroskop Phasenkontrastmikroskop Technische Daten: Optisches System: Anti-Fungus, Unendlichkorrigiert Stativ: stabiler und kippsicherer verbreiteter Druckguss-Fuß für bessere Stabilität. Tubus: Siedentopf trinokular, ergonomisch günstiger Einblickwinkel von 30°, 360° drehbar, Augenabstand verstellbar 52-75 mm Okulare: Weitfeld-Okulare WF 10x/20mm, Anti-Fungus Beschichtung Objektivrevolver: fünffach, nach hinten geneigt und kugelgelagert, 5 Phasenkontrastobjektive: Infinity DIN PH-Plan-Achromatische Objektive, unendlich korrigiert, 10x, 20x, 40x (mit Feder), 60x (mit Feder), 100x (mit Feder) Anti-Fungus Beschichtung Großer Kreuztisch 150mm, mit Präparathalter Kondensor: Dunkelfeld Kondensor N.A. 0,83-0,91 Zusätzlich Abbe-Kondensor NA 1.25 mit Irisblende, Phasenkontrastschiebern. Fokussierung: koaxialer Grob- und Feintrieb für präzise Fokussierung Beleuchtung: Köhler Beleuchtung Extrahelle LED -Full Köhler- Monitor: Hochauflösend 8 Zoll oder 15 Zoll CCD: Hochauflösend 1/3 Zoll, 1024x768 USB bis 1600x1200 Am Monitor zusätzlich ein 10-fach Digitalzoom In den meisten Fällen reicht der 8 Zoll Monitor. Gerade bei großen Vergrößerungen, erhalten Sie ein schärferes Bild. Geeignet als Medizinprodukt, EG-Konform nach EU-Richtlinie 93/42/EWG Klasse 1 -- Einführungspreise--
Wenn Sie Fragen haben, wir beraten Sie gerne 0631-78319 |
|
|
|
Bilder gemacht mit dem Dunkelfeldmikroskop (Dark-Field) Di-Li 1030
 |
 |
|
 |
 |
 |
Bilder gemacht mit Phasenkontrast 60er + 100er Di-Li 1030-P
 |
 |
 |
 |
Dunkelfeldmikroskopie - Dunkelfelddiagnostik - Nativblut
Wenn es darum geht, Objekte zu mikroskopisch
zu betrachten, die im Wesentlichen ohne Kontraste, also deutliche
Farbunterschiede, vorhanden sind, greift man auf die Dunkelfeldmikroskopie
zurück. Achten Sie beim Kauf darauf, dass das Mikroskop
diese Variante unterstützt, damit Sie beispielsweise rote
Blutkörperchen untersuchen können. Hierbei wird das
Licht durch eine Dunkelfeldeinheit schräg durch das Objekt
geleitet. Der eigentliche Lichtstrahl geht am Objektiv vorbei
und nur das vom Objekt gebrochene Licht fällt in das Objektiv
ein, so erhalten Sie ein helles Bild auf dunklem Hintergrund.
Umrisse werden erkennbar, innere Strukturen leider nicht.
Zoom - ja oder nein?
Trinokular
Auch bei einem trinokularen Mikroskop wird das Objekt mit
beiden Augen betrachtet. Allerdings bietet es den Vorteil, dass
ein drittes Okular angebracht ist, das es ermöglicht, über
einen Kameraadapter eine Digitalkamera anzuschließen, die
das im Moment gesehene Bild dokumentiert. Sie können so
ganz entspannt arbeiten, ohne einen ständigen Wechsel vornehmen
zu müssen, sondern haben immer und zu jeder Zeit die Möglichkeit,
ein Bild dauerhaft zu fixieren.
Die Vitalblutuntersuchung nach Prof. Dr. Enderlein (Dunkelfeldmikroskopie)
Die Vitalblutuntersuchung mit dem Dunkelfeldmikroskop
ist eine Diagnoseform, die wichtige Aufschlüsse über
die Funktionsfähigkeit der Blutzellen und über das
innere Milieu des Blutes gibt.
Streng genommen ist die Dunkelfeld-Vitalblutuntersuchung nach
Prof. Enderlein keine wissenschaftliche Methode sondern eine
Betrachtungsweise, da die im Blut zu beobachtenden Phänomene
teilweise völlig unterschiedlich interpretiert werden. Nach
den Forschungsergebnissen von Prof. Dr. Enderlein (1872-1968),
der als Biologe und Zoologe wirkte, gibt es im Blut kleinste
Eiweißkörper (Endobionten), aus denen durch Weiterentwicklung
höher entwickelte Strukturen wie Viren, Bakterien bis hin
zu den Pilzen entstehen können. Die Untersuchung des Vitalblutes
unter dem Dunkelfeldmikroskop gibt Aufschluss über die Blutzellen
selbst, das Plasma und die Endobionten, und zwar in funktioneller
und struktureller Hinsicht. Auch die pathogenen Formen, wie bakterielle
Entwicklungen und Pilzvorstadien, werden im Blut sichtbar.
Die Dunkelfeldmikroskopie benutzt ein spezielles Mikroskop, das die betrachteten Objekte durch indirektes von der Seite her einfallendes Licht betrachtet. Als eine optische Methode können mit der Dunkelfeldmikroskopie Objekte untersucht werden, die aufgrund ihrer geringen Größe weit unter der Wahrnehmungsgrenze des menschlichen Auges liegen und deshalb ohne technische Hilfsmittel nicht oder nur eingeschränkt betrachtet werden können. Insbesonders durchsichtige und kontrastarme Objekte können mit der Methode ohne vorherige Färbung untersucht werden.
Mit dieser Methode können chronische Erkrankungen, Infektanfälligkeit, sich wiederholende bakterielle Probleme und toxische Probleme (z.B. bei Amalgambelastung) untersucht werden. Auch eignet sie sich zur Therapiekontrolle bei biologischen Therapien (Sanumtherapie, homöopathische Therapieformen). Therapietests können für den Patienten sichtbar gemacht werden, indem man zur Blutprobe Medikamente hinzufügt und deren Reaktion weiter beobachtet. Letztendlich ist es mit Hilfe der Dunkelfeldmikroskopie möglich, degenerative Tendenzen im Blut und somit frühzeitige Warnsignale zu erkennen.
Umstritten ist jedoch der Einsatz der Vitalblutuntersuchung mittels Dunkelfeldmikroskopie zur Krebserkennung, wie es von einigen Ärzten und Heilpraktikern im alternativmedizinischen Bereich eingesetzt wird. Nach wissenschaftlichen Studien scheint es mit der Dunkelfeldmikroskopie nicht möglich zu sein, das Vorhandensein einer Krebserkrankung sicher zu erkennen.
Ablauf der Untersuchung
Nach der Entnahme eines kleinen Bluttropfens aus der Fingerkuppe
oder dem Ohrläppchen wird dieser sofort mit einer 1200-fachen
Vergrößerung unter dem Dunkelfeldmikroskop betrachtet.
Für den Patienten besteht bei der Untersuchung auch die
Möglichkeit, einen Blick durch das Mikroskop zu werfen,
bevor das Blutbild mit dem Arzt besprochen wird. Der Arzt selbst
überprüft das Blut noch in gewissen Intervallen, um
aus der Degenerationsgeschwindigkeit Rückschlüsse auf
die Zellresistenz, degenerative Neigung und das Immunsystem zu
erhalten.
Die Beurteilung des Blutbildes unter dem Dunkelfeldmikroskop ist sehr schwierig und kann von verschiedenen Therapeuten jeweils unterschiedlich interpretiert werden. Die Methode sollte deshalb nur von erfahrenen und speziell ausgebildeten Ärzten und Therapeuten vorgenommen werden. Die Untersuchung ersetzt keinesfalls die herkömmlichen Laboruntersuchungen des Blutes und sollte eher als wichtige zusätzliche Informationsquelle über mögliche degenerative Vorgänge im Blut gesehen werden.
Wenn Sie Fragen haben, wir beraten Sie gerne 0631-78319.
|
|
|
 |

|
Nominiert -European Enterprise Award-


